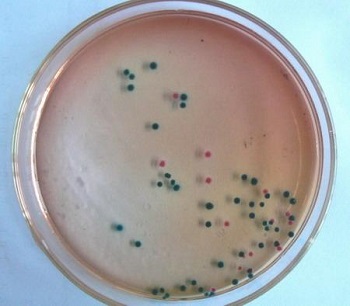
WPM培养基

WPM培养基
|
|
|
- CAS号:
- 英文名:
- WPM Medium
- 英文别名:
- CN150956;WPM Medium
- 中文名:
- WPM培养基
- 中文别名:
- WPM培养基;WPM培养基(含糖和琼脂);WPM培养基(不含硝酸钙);WPM培养基(不含糖和琼脂)
- CBNumber:
- CB24849829
- 分子式:
- 分子量:
- 0
- MOL File:
- Mol file
|
|
|
WPM培养基性质、用途与生产工艺
WPM培养基是1981年由Lloyd和McCown为山月桂茎尖培养专业设计,根据MS培养基改良而来,相对MS培养基而言,使用了硫酸钾替换了KNO3,NH4NO3的含量也降低到了MS培养基的1/4,氮盐也主要以硝酸钙的形式供应。
木本植物用培养基(WPM)实验方法实验内容:
1.称量→溶化→调pH→过滤→分装→加塞→包扎→灭菌→无菌检查
2.干热灭菌:装入待灭菌物品→升温→恒温→降温→开箱取物
3.高压蒸汽灭菌:加水→装物品→加盖→加热→排冷空气→加压→恒压→降压回零→排汽→取物→无菌检查
4.过滤除菌:组装灭菌→连接→压滤→无菌检查→清洗灭菌
WPM培养基可用于植物组织的培养。
产品用法:称取本品2.7g,加热溶解于1000ml蒸馏水中,分装,116℃高压灭菌30min,备用。
称取本品2.14g,另取硝酸钙0.56g,加热溶解于1000ml蒸馏水中,分装,116℃高压灭菌30min备用。
WPM培养基
上下游产品信息
上游原料
下游产品
WPM培养基 相关搜索:
- 植物组织培养-植物组织培养基
- 培养基
- WPM培养基(不含糖和琼脂)
- WPM培养基(含糖和琼脂)
- WPM培养基(不含硝酸钙)
- WPM培养基
- CN150956
- WPM Medium